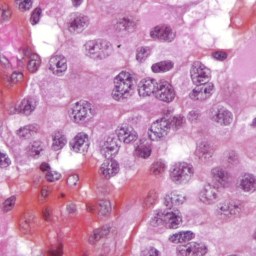

WHY THIS MATTERS IN BRIEF
New construction technologies are helping companies build homes in new ways faster and cheaper than ever before.
Interested in the Exponential Future? Connect, download a free E-Book, watch a keynote, or browse my blog.
Earlier this year and hot on the heels of a family moving into a 3D printed home in France, the US Marines ambitious project to 3D print barracks, and Dubai’s ambitions to 3D print an 80 storey skyscraper starting in 2020, I shared details about an ambitious project to 3D print an entire community somewhere in South America. And now, a six or so months on that plan has now been put into action and the non-profit behind it has revealed what they’re calling “the world’s first 3D printed community” in rural Mexico.
The project, which was run by Icon and Échale, is located in Tabasco in Mexico and by the end of it the two companies aim to have printed 50 brand new homes for families in the area who are living in extreme poverty and often in dangerous and rickety makeshift shelters.
Take a look for yourself. Courtesy: New Story
So far the first two homes have been completed and the first families will receive them at a zero interest, zero profit mortgage costing around 400 Mexican Pesos, or about US$20 per month, which will run for seven years.
The construction process for the homes was essentially based on the same principles as other 3D printed projects I’ve discussed before and involved Icon’s Vulcan II printer that extruded cement out of a nozzle layer by layer until the shells of the homes were completed, a process that took about 24 hours per house. Then when the shells were complete human builders came in and finished them off by adding rooves, windows, and doors. All that said though the project wasn’t without challenges.
“The 3D printer for homes, called the Vulcan II, is designed to work under the constraints that are common in rural locations, but the journey has not been easy,” says New Story. “Power can be unpredictable and local rainfall has often flooded access roads to the construction site. This printer, designed to tackle housing shortages for vulnerable populations, is the first of its kind.”
The single storey homes measure 500 sq ft (46.5 sq m) and look comfortable and well made and are divided into two bedrooms, a living room, a kitchen, and a bathroom. There’s also a small porch area for dining outside.
They also come with electrical and water hookups and, according to New Story, have been engineered “above the standard safety requirements to ensure they will withstand both the local seismic conditions, and the test of time.”
“We are living a historic moment, having the first community of 3D printed homes being built,” says Gretel Uribe, Development Director, Échale. “But more than the technological accomplishment that this represents, which feels like science fiction meeting reality, I would like to point out that this technology is being developed and used to bring adequate housing to the most vulnerable families. I think this project is a lesson that if we come together to work, join talents and resources, and lead them to solve real problems, the dream of sustainability and social fairness is achievable.”
New Story declined to share the actual construction cost of the homes at this time but is aiming to increase efficiency and lower cost as the project progresses, and they expect that the remaining 48 homes will be filled with families by next year.
Source: New Story